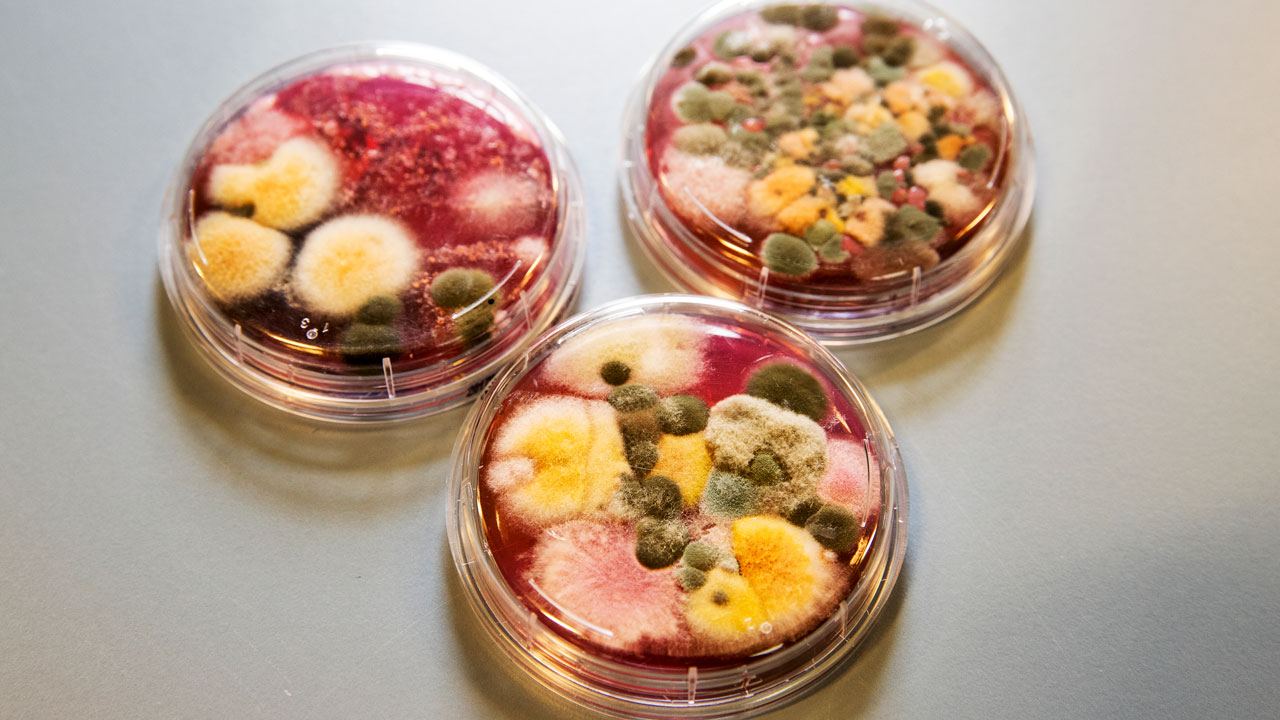
Petri-schalen met diverse microbiële kolonies voor endotoxine-analyse in Tetra Tech-laboratorium – schimmels en bacteriën zichtbaar

Luchtmetingen bacteriën gisten en schimmels

De gemiddelde Nederlander brengt 80 tot 90% van zijn tijd binnen door. Thuis, maar ook op kantoor, op school, in winkels, ziekenhuizen, verpleeghuizen etc. Het is dan ook van het grootste belang dat het binnenmilieu in deze gebouwen van een dusdanige kwaliteit is dat gebouwgebruikers zich gezond en comfortabel voelen. Dat heeft ook een positief effect op de productiviteit.
Bepalen van de binnenluchtkwaliteit
Een goede graadmeter voor het bepalen van de binnenluchtkwaliteit in kantoren is de aanwezigheid van micro-organismen. Veel micro-organismen die normaal gesproken buiten in de atmosfeer voorkomen, worden ook binnen in gebouwen aangetroffen. Ze worden binnengebracht door mens en dier, maar vooral door luchtstromingen. Deze luchtstromingen worden veroorzaakt door het heen en weer lopen van mensen, luchtbehandelingsystemen en drukverschillen. Blootstelling aan micro-organismen en hun giftige bijproducten vindt plaats via ademhaling en contact. Via de ademhaling treden over het algemeen de ernstigste gezondheidseffecten op. Zo kunnen schimmels (schimmelsporen) en bacteriën allergische reacties veroorzaken.

Opgelucht - Samen werken aan veilige en gezonde werkplekken
Bij Tetra Tech staan wij voor veilige en gezonde werkomgevingen. Een van onze meest impactvolle initiatieven is Opgelucht, een platform dat volledig is gewijd aan het voorkomen van blootstelling aan gevaarlijke stoffen op de werkvloer. Samen met de Long Alliantie Nederland (LAN) zetten wij ons in om bedrijven en werknemers bewust te maken van de risico’s en hen te voorzien van de kennis en middelen om deze risico’s effectief te beheren.
Met Opgelucht bieden wij inspirerende en informatieve magazines, vol met praktijkvoorbeelden, adviezen van experts, en de laatste inzichten in arbeidshygiëne. Ons doel is om bedrijven te ondersteunen in het nemen van proactieve maatregelen, zodat beroepsziekten voorkomen kunnen worden en de gezondheid van werknemers gewaarborgd blijft. Neem snel een kijkje op www.opgelucht.nl.


